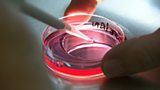

BBC ALBA Schedule
Schedule
Morning
06:00
Alba Today—26/02/2011
BBC Alba joins Radio nan Gàidheal, the BBC's Gaelic language radio service.
Afternoon
14:30
Peppa—Series 1, Leasan Dannsa
31/52Leasan bho Madame Gazelle. Peppa learns her ballet steps.(R)
14:35
Igam Ogam—Crios Ort (Faster)
16/26Igam Ogam and Rolag build themselves a tricycle to whizz around on.(R)
14:45
Cobhair bho Anna—Series 2, An Garadh a' fàs (The Garden)
16/26Anna and the gang help Katie the kitten.(R)
14:55
Meusaidh—Episode 11
11/26Follow the amazing adventures of Meusaidh.(R)
15:05
Bigeil—Series 1, Episode 11
11/20The three little mice play, sing and listen to a story.(R)
15:25
Storaidh Bho Na Bonnachain—Series 1, 23/02/2009
Jack reads a story to his puppet friends in the Gingerbread House.(R)
15:30
Dè a-nis?—Series 18, Episode 19
19/24Siobhan spends another day with the animals - but what will her task be?(R)
16:30
Club TV—Series 2, Episode 5
5/7Exclusive interviews, match action and a behind-the-scenes look at Celtic and Rangers FC.(R)
17:30
Scottish Premier League—2010-2011, Hamilton V Dundee Utd
Geama slàn bho Prìomh Lìog na h-Alba. The latest full-match coverage from the SPL.
Evening
19:30
An t-Ionnsachadh Og—Hostels
1/3The experiences of Islanders who left home to pursue their education in Portree.
20:00
Eòrpa—Series 18, Episode 19
19/24Reporting on the most interesting stories from around Europe.(R)
20:30
Tir nan Og—Mairead Maclennan
6/19Mairead Maclennan conjures up his Tìr nan Òg.(R)
21:00
A' Comharrachadh Bliadhna nan Oran (Celebrating the Year of Song)
Bringing together performances from the whole of 2010 to mark the BBC Year of Song.
22:30
Horo Gheallaidh—Sreath 3, Episode 2
2/11Performances from Nanci Griffith, harmonica genius Brendan Power and Brian O hEadhra.(R)
23:00
Ceol Aig A Chaisteal—Series 1, Episode 5
5/8Ceol is orain aig Caisteal an Tulaich. Music and song from Tulloch Castle.
23:25
Fraochy Bay—Series 1, Tha cuibhlichean a ghaoil a' cuir charan (The Wheels of Love Are in the Air)
2/20Love, loss and added extras are in the air for Miss Harper, the teacher.(R)
23:30
Scottish Premier League—2010-2011, Hamilton V Dundee Utd
Geama slàn bho Prìomh Lìog na h-Alba. The latest full-match coverage from the SPL.(R)
Late
01:30
Alba Today—27/02/2011
BBC Alba joins Radio nan Gàidheal, the BBC's Gaelic language radio service.